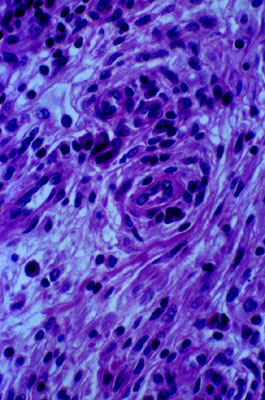

Syphilitic aortitis
Click picture to enlarge. Close window to return
In the deep media, and adventitia, the small blood vessels (vasa vasorum) are surrounded by infiltrates of plasma cells and lymphocytes and the endothelial cells appear swollen. This obliterative endarteritis leads to focal ischemic necrosis of the wall of the aorta.